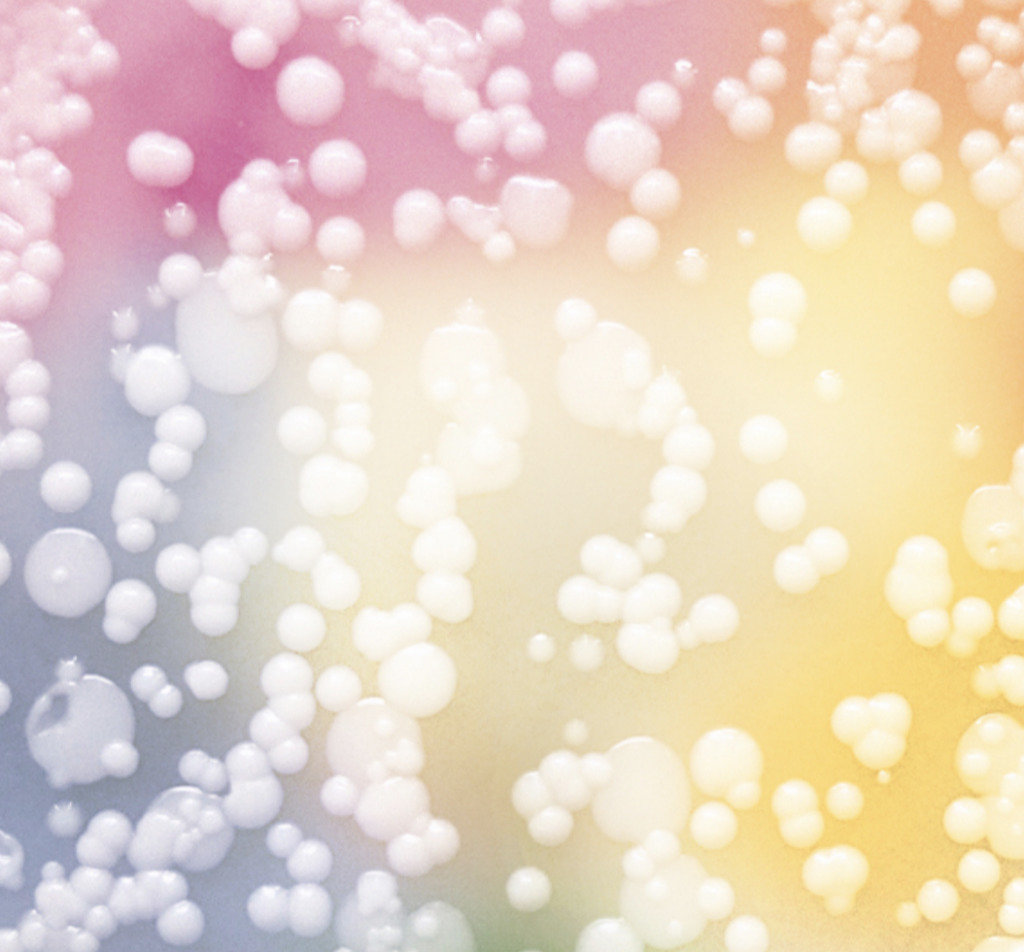

Kingdom Supercultures, the New York startup specialising in microbial cultures, is gearing up to unlock new plant-based foods and drinks with its “Supercultures”. Securing $25 million in a Series A round, the company will use the proceeds to expand its portfolio of ingredients that could help elevate the flavours and textures of vegan yogurt, cheese, and even wine and beer.
Kingdom Supercultures has raised $25 million in its Series A round led by New York-based early-stage investors Shine Capital. Other VCs joining the round include Valor, Lux, and Digitalis, among others, as well as the founders of fellow food techs and brands like Daring Foods, Good Culture, Hungryroot, and Rxbar.
It comes after the company’s initial $3.5 million seed funding backed by a number of tech VCs, notably including Sequoia and Y Combinator. Proceeds from the latest round will help finance Kingdom’s plan to “revolutionise plant-based foods” with its natural microbial cultures.
Supercultures
Founded in 2019, the self-described biodesign company harnesses natural microbes and assembles them into new combinations of ingredients that could help unlock and improve CPG products, from food and drinks to personal care.
In the realm of food, these combinations of microbial-based ingredients, which Kingdom dubs its Supercultures, can help make vegan dairy products such as yogurt and cheese taste more like real dairy. Or transform the taste of low-alcohol wines and beers, adding depth and fullness. Kingdom sells its library of natural microbes to CPG manufacturers, helping them create better-tasting natural plant-based foods, which are in high demand.
Within the US alone, plant-based retail sales have doubled to top $7 billion in 2020, and with the global flexitarian population reaching 4 in 10 consumers, there are no signs of slowdown in the vegan food market.

The Series A financing will help Kingdom double down on its R&D to offer more Superculture ingredients and help CPG brands meet the changing preferences of mainstream consumers.
“The last few years have seen tremendous growth in demand for consumer goods that are healthier and more sustainable,” shared Kingdom CEO Kendall Dabaghi. “This funding will allow us to meet the need for novel, natural ingredients by continuing to build out our world-class team and advancing our Superculture R&D.”
Fine-tuning vegan products naturally
One of the unique selling points of Kingdom’s natural microbes is the ability to tailor brands’ food and drinks and improve the sensorial experience of vegan food in a natural way, catering to the growing swathes of health-conscious consumers who are driving the clean-label movement.
“Much in the same way that the largest ingredient companies built out libraries of artificial chemical isolates to change the properties of consumer goods, Kingdom Supercultures is doing the same thing with microbial strains found in nature,” said the startup.

CSO Ravi Sheth further explained that its technology represents an “entirely new field of science and class of ingredients by working with biology at the ecosystem and microbiome level,” adding that its microbial platform can offer sustainable ingredient “breakthroughs” to its clients “all without genetic modification.”
This was the reason why lead investor Shine Capital decided to back Kingdom. Mo Koyfman, founder and general partner of the firm, said Kingdom will “catalyze our move towards natural food, beverage, and beauty products.”
“Particularly as the plant-based market continues to expand, Kingdom Supercultures is poised to enable large and small brands alike to deliver the highest quality natural products to consumers,” Koyfman added.
One food tech that is already making breakthroughs using microbial technology is Chicago-based Aqua Cultured Foods, which recently debuted what it says is the world’s first-ever whole muscle cut vegan seafood alternative made using microbial fermentation.
According to the company, its minimally-processed vegan seafood range, which includes tuna, shrimp, and calamari, to name a few, boasts a similar nutritional profile to real cod, as well as higher fibre, and is free of all the main 8 allergens and saturated fats.
Lead image courtesy of Pexels.



